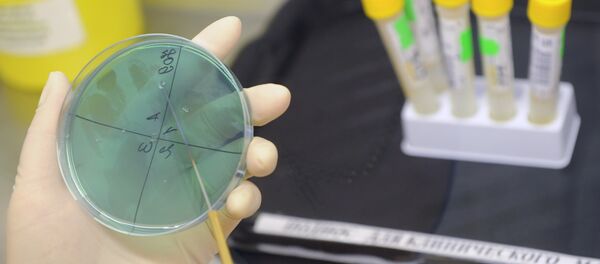
俄羅斯就炭疽桿菌樣本誤發事件質疑美國生物安全體系 - 俄羅斯衛星通訊社

據此前報道,活性炭疽桿菌被誤送至美國18個州的51所實驗室和其他國家(韓國、澳大利亞和加拿大)的3所實驗室。
沃倫還表示:"現31人被隔離,被隔離者數量尚無變化。"他說,出現活性炭疽桿菌的國家名單沒有發生改變。
五角大樓正在對情況展開調查,發現活性炭疽桿菌是由一軍方實驗室送出。計劃將在近幾周內完成調查。
沃倫還表示:"現31人被隔離,被隔離者數量尚無變化。"他說,出現活性炭疽桿菌的國家名單沒有發生改變。
五角大樓正在對情況展開調查,發現活性炭疽桿菌是由一軍方實驗室送出。計劃將在近幾周內完成調查。

京公網安備11010502053235號